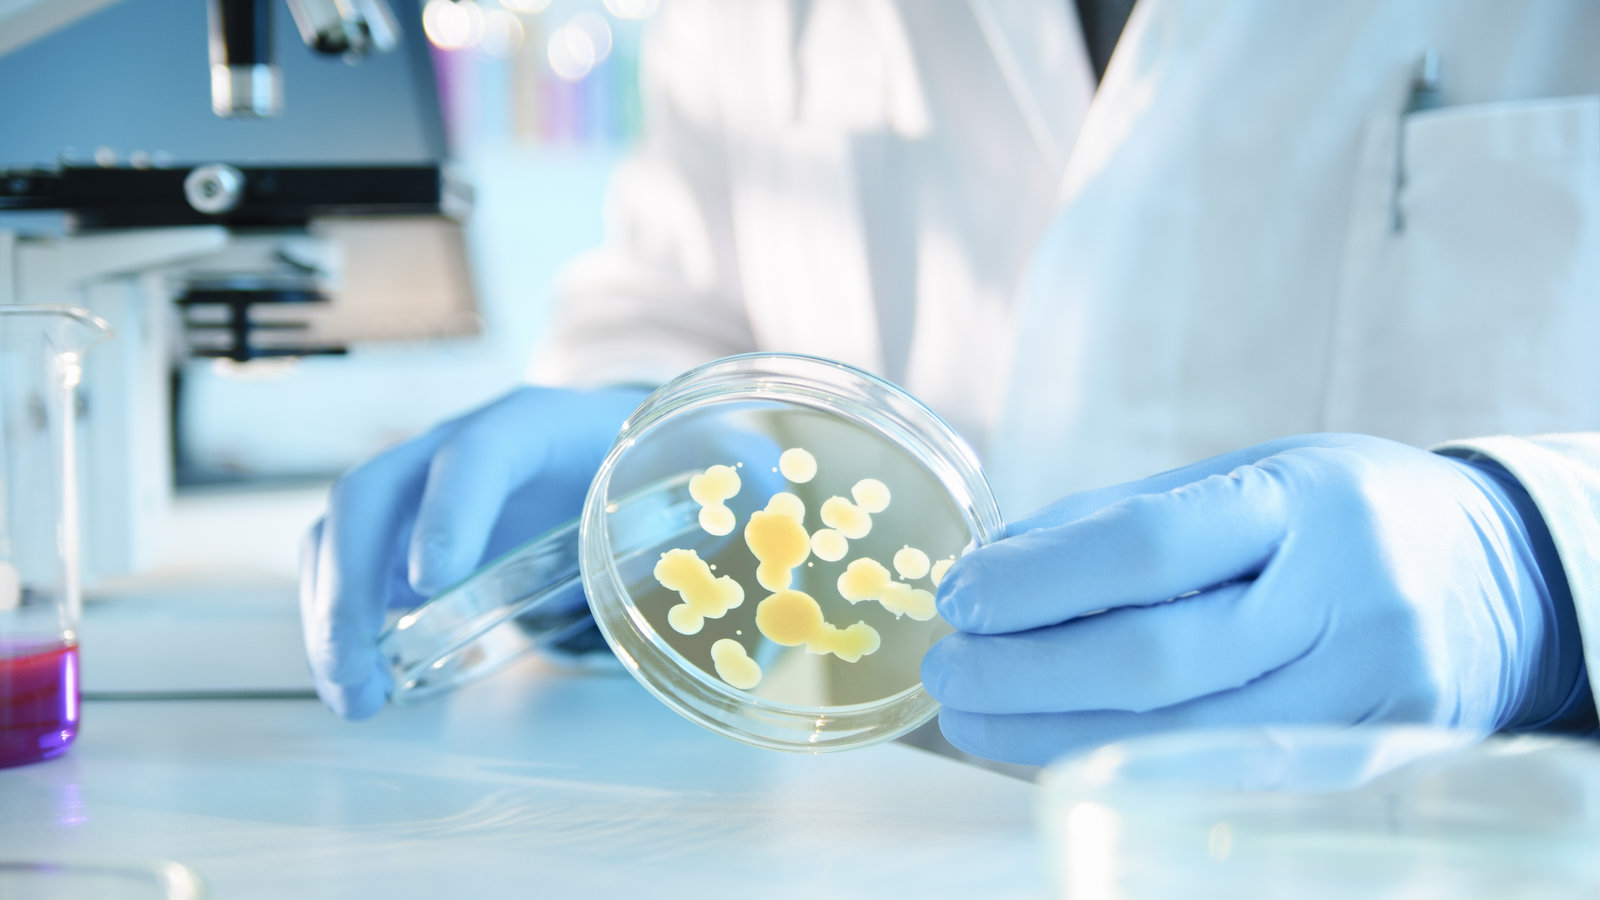
stm large

Bienvenue
Société Tchadienne de Microbiologie (SoTM)
« One World, One Health »
Promouvoir l’excellence scientifique en microbiologie au service de la santé publique au Tchad

objectifs stratégiques
De la promotion de la science à la création de synergies internationales, nos objectifs tracent le chemin vers une microbiologie tchadienne d’excellence.
Nos Missions
De l’organisation d’événements à la contribution aux politiques publiques, nos missions définissent notre action quotidienne au service de la microbiologie tchadienne..
Rejoignez le réseau des microbiologistes tchadiens
Votre adhésion, c’est bien plus qu’une cotisation : c’est un engagement pour la science, un investissement dans votre carrière et une contribution à la santé publique.

Investissez dans votre avenir professionnel. Adhérez maintenant
“Fondée en 2024, la Société Tchadienne de Microbiologie rassemble médecins, vétérinaires, chercheurs et enseignants autour d’une vision commune : faire de la microbiologie un pilier du développement du Tchad.”

BAN-BO BEBANTO ANTIPAS,
PhD, Président du comité
4.8/5
1860 Reviews
4.6/5
1630 Reviews
4.7/5
2100 Reviews
Notre Expertise
De l’humain à l’environnement, de la clinique au laboratoire, nos expertises couvrent tous les champs de la microbiologie moderne.
La SoTM réunit des experts dans tous les domaines de la microbiologie. Cette diversité fait notre force et nous permet d’apporter des réponses pertinentes aux défis sanitaires, environnementaux et agricoles du Tchad.
Microbiologie médicale

Microbiologie vétérinaire

Microbiologie environnementale

Microbiologie des sols

Microbiologie alimentaire

Résistance aux antimicrobiens
Des services pensés pour votre développement professionnel
Formation continue
Des formations adaptées aux besoins des professionnels de la microbiologie : techniques de diagnostic, nouvelles méthodologies, gestion de laboratoire, biosécurité. → Formez-vous avec les meilleurs experts → Obtenez des attestations reconnues → Tarifs préférentiels pour les membres
Conseil et expertise
La SoTM met à disposition son réseau d'experts pour conseiller les institutions, entreprises et organisations. → Expertise en santé publique → Conseil en gestion de laboratoire → Appui à la recherche
Networking et opportunités
Accédez à un réseau dynamique de microbiologistes, créez des collaborations, découvrez des opportunités professionnelles. → Annuaire des membres → Événements de networking → Opportunités de collaboration
Publications scientifiques
Publiez vos recherches dans nos bulletins, présentez lors de nos congrès, contribuez à nos référentiels. → Plateforme de diffusion scientifique → Visibilité de vos travaux → Reconnaissance par les pairs
Votre curiosité d'aujourd'hui façonnera les découvertes de demain
Etudiants, Jeunes chercheurs, Professionnels, Institutions… Ensemble, faisons avancer la science

Rejoindre la SoTM a transformé ma pratique professionnelle
« L’accès aux formations, le réseau de pairs et les opportunités de collaboration m’ont permis de développer considérablement mes compétences. Aujourd’hui, je contribue activement à l’amélioration des pratiques dans mon laboratoire »



Subsribe To Our Newsletter
Restez en contact avec nous pour recevoir les dernières actualités et offres spéciales.
Addresse
Qtier Farcha, N'Djamena, Tchad
Call Us
+235 65 58 80 57
Email Us
info@sotm-td.org







